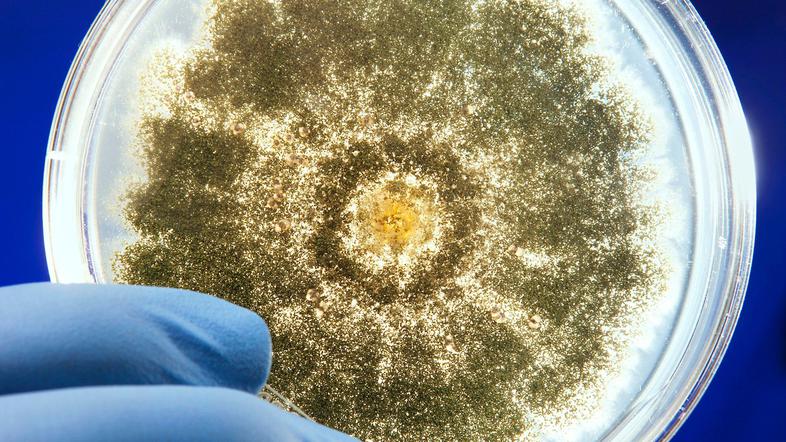

Učinki aflatoksinov na zdravje ljudi
Aflatoksini se v jetrih presnovijo v zelo reaktiven metabolit, ki lahko reagira z beljakovinami in tako poškoduje oziroma uniči jetrne celice. Na našem inštitutu za javno zdravje pojasnjujejo, da genotoksični - kar pomeni poškodbo genskega materiala in rakotvorni. Verjetno povzročajo tudi razvojno in imunotoksičnost, dodajajo.
Aflatoksini se največkrat pojavljajo v živilih kot so zemeljski oreščki, drevesni oreščki (npr. pistacije, lešniki in orehi), koruza, riž, fige in drugo suho sadje, začimbe, surova rastlinska olja, kakavova zrna in so posledica onesnaženja s plesnimi pred ali po nabiranju.
Poleg vnosa z zaužitjem hrane so tveganja za zdravje povečana tudi pri dotiku s kožo in vdihavanju onesnaženega zraka pri delu s plesnimi okuženo hrano in krmo. Enkratni visoki odmerki povzročajo akutne zastrupitve z aflatoksini, dolgo časa trajajoči nizki odmerki pa povzročajo kronične zastrupitve.
Podatki o živilu:
Opis živila: koruzna pokovka
Ime: Seeberger Popcorn-Maise
Pakiranje: 500 g
Sarža in rok uporabe: L435136, rok uporabe 01/2020
L435137, rok uporabe 02/2020
L437018, rok uporabe 02/2020
L437019, rok uporabe 02/2020
Poreklo: Nemčija